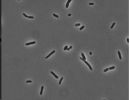

Geomikrobiologie

AG Geomikrobiologie:
Wir untersuchen Stoffwechselwege und Stoffflüsse in Mikroorganismen und mikrobiellen Gemeinschaften. Der Schwerpunkt der Forschung liegt dabei auf den weltweit größten Brackwassermeeren – der Ostsee sowie dem Schwarzen Meer. Besonders interessiert uns auf welche Weise Mikroorganismen in diesen Ökosystemen ihre Energie generieren und welchen Einfluss dieses auf die damit verbundenen Stoffflüsse hat.
Unsere Forschungsfragen sind hierbei:

Sulfid-oxidierende Bakterien: Verbreitung in den Sedimenten der Ostsee und Identifikation der Umweltbedingungen die das Auftreten von Beggiatoa und/oder Desulfobulbaceae (Kabel) Bakterien fördern. Diese beiden Bakteriengruppen weisen sehr ähnliche und sehr ungewöhnliche Wege der Energiegewinnung auf.

Assoziationen zwischen Cyanobakterien und heterotrophen Organismen:Welche Vorteile bietet ein Zusammenleben? Wer versorgt wen mit welchen Nährstoffen?

Kultivierung, Anreicherung und Isolierung von Bakterien aus der Redoxzone des Schwarzen Meeres. Forschung an anaeroben mangan- und schwefelabhängigen Stoffwechselprozessen.
Verteilung von polyphosphathaltigen Mikroorganismen in Redoxbereichen geschichteter Wassersysteme. Relative und quantitative Messungen von bakteriellen Polyphosphaten in nanomolaren Konzentrationsbereichen.
Team
Leiterin:
Post-Docs:
Doktoranden/Doktorandinnen:
Technikerin
Projekte
SECOS – The Service of Sediment in German Coastal Seas (Aufgabe der Sedimente der deutschen Küstengewässer)
Link: http://secos.deutsche-kuestenforschung.de/
Bakterielle Gemeinschaften in Sedimenten der Ostsee: Verknüpfung der bakteriellen Physiologie mit ihrer Ökologie